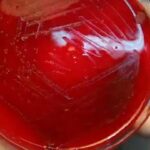
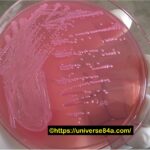

Tag: serotyping
Streptococcus pneumoniae-Introduction, Morphology, Pathogenicity, Lab Diagnosis, Treatment, Prevention, and Keynotes
Introduction Streptococcus pneumoniae, often referred to as pneumococcus, is a...
Introduction Streptococcus pneumoniae, often referred to as pneumococcus, is a...
Escherichia coli: Introduction, Morphology, Pathogenicity, Lab Diagnosis, Treatment, Prevention, and Keynotes
Introduction Escherichia coli, often abbreviated as E. coli, is a...
Introduction Escherichia coli, often abbreviated as E. coli, is a...
Shigella sonnei: Introduction, Morphology, Pathogenicity, Lab Diagnosis, Treatment, Prevention, and Keynotes
 Introduction Shigella sonnei is a gram-negative bacterium and one of...
Introduction Shigella sonnei is a gram-negative bacterium and one of...
